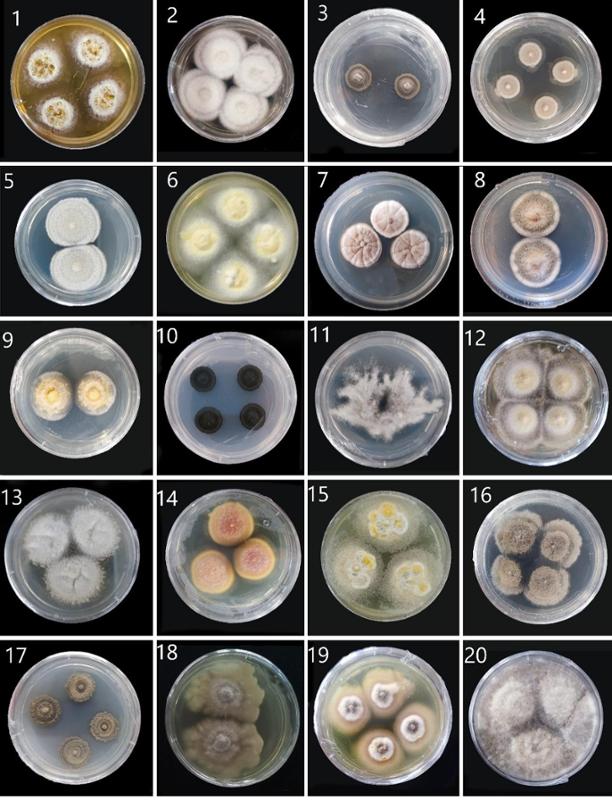
image2.jpeg

食药用真菌资源多样性及其开发利用团队首次系统整理了全球范围内已报道的蕨类植物相关真菌名录,系统梳理了该类真菌的历史背景、重要性、多样性、数量、区域分布、生活方式及宿主特异性等多个方面,并在贵州喀斯特地区发现25 个蕨类植物真菌新物种,为理解维管植物与真菌的早期协同进化提供了关键证据。研究成果以“A worldwide checklist and morpho-molecular systematics of fungi associated with pteridophytes”为题发表于真菌学领域国际顶级期刊Fungal Diversity(Top期刊,中科院1区,IF=24.5)。
论文链接:https://doi.org/10.1007/s13225-025-00554-1
该研究得到了国家自然科学基金(32060013)、贵州省农业微生物全省重点实验室、贵州理工学院高层次人才启动基金等项目的资助。贵州理工学院与泰国皇太后大学(Mae Fah Luang University)联合培养的博士研究生张静宜(系贵州理工学院生物制药专业2014级学生)为第一作者,学院卢永仲教授为论文唯一通讯作者。贵州理工学院为该成果第一完成单位,皇太后大学、贵州省农业科学院、贵州大学、深圳大学、大理大学、电子科技大学等单位参与了相关研究工作。

图1 蕨类植物相关真菌的菌落形态特征
首次提供全球蕨类植物相关真菌详细清单
研究团队通过系统整理文献资料和数据库信息,编制了全球蕨类植物相关真菌的详细清单。该清单涵盖了1706种真菌,分布于11门34纲104目248科632属。这一清单为真菌学家提供了宝贵的数据基础,有助于进一步研究蕨类植物相关真菌的多样性和分布特征。
图2 蕨类植物相关真菌菌株形态特征
在中国贵州发现多种真菌新物种
研究中,团队在我国贵州省收集了81个蕨类植物样本,通过形态学描述和多基因系统发育分析,共鉴定出48种属于子囊菌门的真菌,其中25种为新物种。这些新物种在形态和基因层面均展现出独特的特征。

图3 贵州喀斯特地貌蕨类植物相关真菌新物种的孢子多样性
探讨真菌与蕨类植物的相互作用
研究深入分析了真菌与蕨类植物之间的相互作用,揭示了真菌在蕨类植物生态适应中的潜在作用。通过观察真菌的生活方式转换、宿主特异性和宿主偏好性,研究发现某些真菌在蕨类植物的不同部位表现出特定的生态适应性。这些发现为理解真菌与植物之间复杂的相互关系提供了新的线索。
推动真菌学与植物学的交叉研究
该研究不仅丰富了真菌学的分类和系统学研究,还为植物学研究提供了新的视角。结果表明,蕨类植物作为古老的维管植物之一,其与真菌的共生关系可能代表着植物与真菌之间最早的共生形式之一。这一发现为研究植物的陆地适应和进化提供了重要参考。
未来研究方向
研究团队指出,全球蕨类植物相关真菌的多样性仍远未被完全揭示。据估计,目前仅约8%的蕨类植物相关真菌被发现和记录,剩余92%的真菌仍有待探索。未来的研究将重点关注真菌的生态功能、次级代谢产物以及其在有害生物防控和药物开发中的潜在应用。
该研究得到了国家自然科学基金(NSFC 32060013)、贵州省农业微生物全省重点实验室、贵州理工学院高层次人才启动基金等项目的资助。贵州理工学院与泰国皇太后大学(Mae Fah Luang University)联合培养的博士研究生张静宜(系贵州理工学院生物制药专业2014级学生)为第一作者,学院卢永仲教授为论文唯一通讯作者。贵州理工学院为该成果第一完成单位,皇太后大学、贵州省农业科学院、贵州大学、深圳大学、大理大学、电子科技大学等单位参与了相关研究工作。